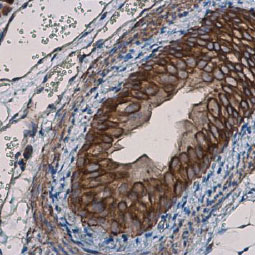
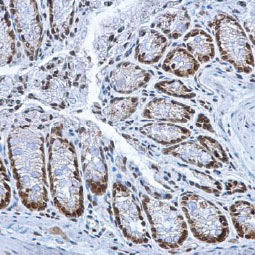

Cell biology is the study of cell structure and function. This includes the most general properties shared by all cells to the specific, highly complex functions unique to specialized cells.
There are an array of research subspecialties within the cell biology field. One is the study of cell energy and the biochemical mechanisms that support cell metabolism. Another focuses on the structure of cell components, known as subcellular compartments or organelles. A third looks at the cell cycle, the progression of cell phases beginning and ending with cell division separated by periods of growth and DNA replication. Finally, there is great interest in the mechanisms associated with cell death, including apoptosis, necrosis, and autophagy. Defining how the molecular mechanisms characteristic of one of these fields influences the others allows scientists to analyze cellular behaviors in more complex ways.